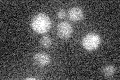
YOR187W

View description
Mitochondrial translation elongation factor Tu; comprises both GTPase and guanine nucleotide exchange factor activities, while these activities are found in separate proteins in S. pombe and humans
Localization:
Intensity:
Fold change:
Significance:
-
C’ GFP library in SD

mitochondria19.17 -
N' NOP1pr-GFP in SD

N/A0 -
N' TEF2pr-mCherry in SD

N/A0 -
N' NATIVEpr-GFP in SD

N/A0 -
N' TEF2pr-VC and Cyto-VN in SD

N/A0 -
C’ GFP library in SD+DTT

mitochondria16.50.86No -
C’ GFP library in SD+H2O2

mitochondria17.30.9No -
C’ GFP library in Starvation Media
mitochondria13.870.72No -
C’ GFP library on the background of Pup2-DaMP

mitochondria -
C’ GFP library on the background of CCT mutant

mitochondria16.56120.863461No
